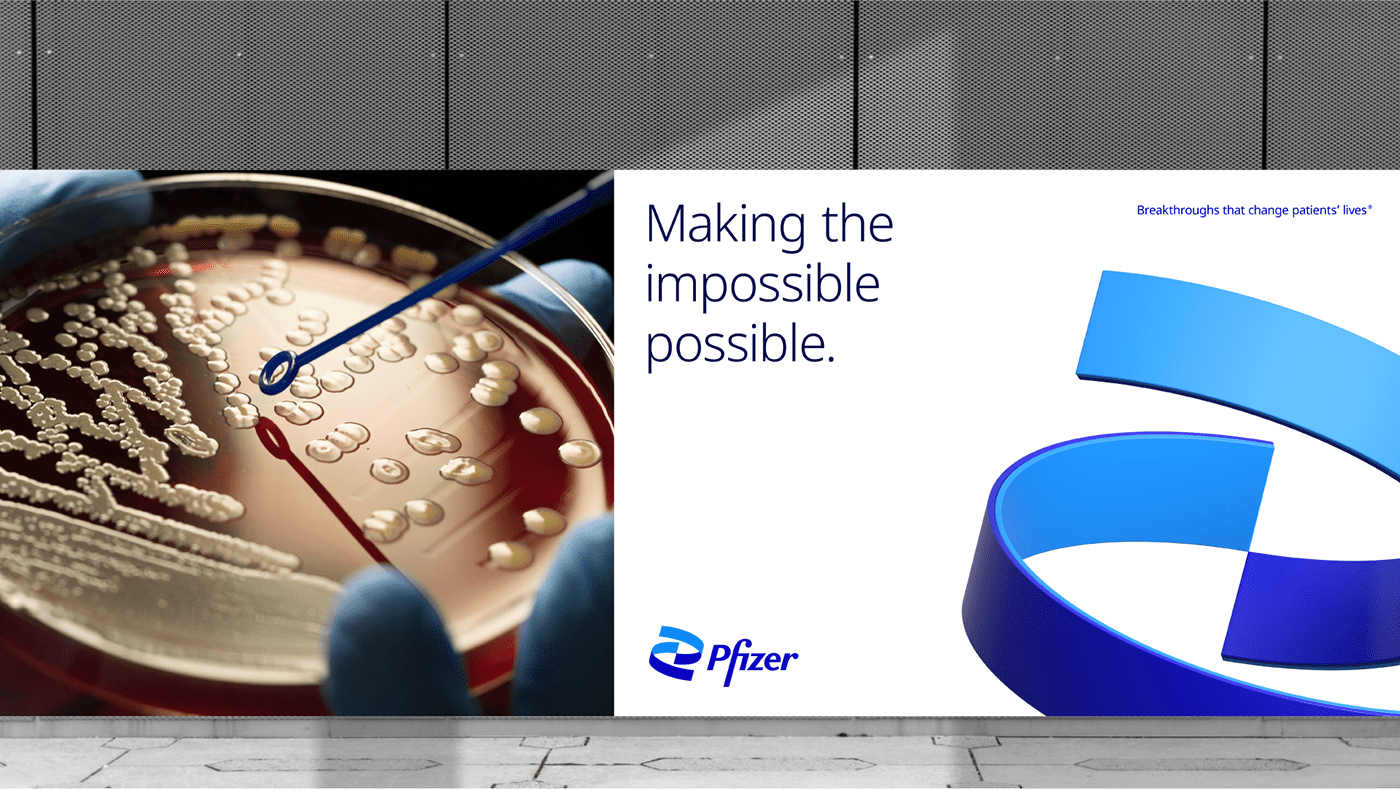
深圳VI設計公司.png

THE VOICES FROM THE BRAND WORLD
來自品牌世界的聲音
每家深圳vi設計公司在進行VI設計之前都會提前策劃好設計方案,在深圳vi設計公司里會由資深品牌總監作為指導進行系統化的vi設計方案輸出。深圳VI設計公司當然也是不例外的。下面給大家說一下深圳VI設計公司的VI設計策劃方案。
首先是明確VI設計的目的是什么。這個是要向甲方企業進行了解的。當然了,大多企業需要VI設計也無非是傳播企業的經營理念與文化、擴大企業的知名度、塑造企業的形象等等這些方面的目的。然后呢,便是設計的原則了。深圳VI設計公司堅持強化視覺沖擊、符合大眾審美、突出企業特色等原則,這樣設計對企業的幫助是有很大的作用的。
深圳VI設計公司的設計主要內容是三個系統即基礎系統、辦公應用系統、環境應用系統。接下來便是項目分組,每個組負責不同的部分,共同完成VI設計項目。設計師么的工作便是進行設計、修正,直到達到要求為止。設計中要重視色彩與風格的相統一,這個是具有強烈的視覺沖擊的,好的形象能夠讓消費者留下印象。
當項目的各個部分都完成后進行最后的審查、修正,當確認無誤后,便會交接給甲方企業。當甲方企業滿意時,那么這個為客戶的VI設計項目便成功完成,如果甲方企業有不滿意的地方要求退回修正,那么就要繼續修正,直到甲方企業滿意為止,這樣才算是完成了這個項目。以上的這些便是深圳VI設計公司進行VI設計時的策劃方案。
VI設計如何讓企業提升市場競爭力?